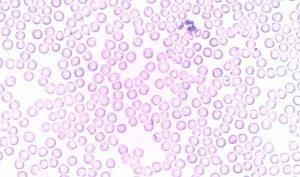
Cómo reducir los leucocitos altos de forma natural Cómo reducir los leucocitos altos de forma natural

La leucocitosis se puede definir como el aumento de leucocitos en la sangre, unas células también conocidas con el nombre de glóbulos blancos que se ocupan de luchar contra las enfermedades.
Las causas más comunes de la leucocitosis suelen ser las infecciones, las gripes, el consumo de ciertos medicamentos, el estrés, las alergias o la enfermedades inflamatorias.
Aunque es imprescindible que acudas a la consulta de tu médico para determinar qué ha propiciado el aumento de glóbulos blancos en tu organismo, existen algunos trucos que te serán de ayuda si quieres saber cómo reducir los leucocitos altos de forma natural y fortalecer el sistema inmunológico.
Consumir alimentos ricos en vitamina C
La vitamina C es una sustancia magnífica para fortalecer el sistema inmunológico y prevenir enfermedades. Además, posee un efecto antiinflamatorio que evitará la aparición de dolencias tales como la artritis, la cual puede aumentar el número de leucocitos en la sangre.
Encontrarás vitamina C en la naranja, el limón, el kiwi, la fresa, la papaya, la guayaba, el pimiento rojo, el perejil y las verduras de hoja verde.
Apostar por los antioxidantes
Los antioxidantes combaten los radicales libres, unas moléculas que pueden dañar las células, acelerar el proceso de envejecimiento y aumentar el riesgo de padecer enfermedades.
Si te preguntas cómo reducir los leucocitos altos de manera natural y gozar de una salud de hierro acuérdate de incluir antioxidantes en tu dieta y de consumir ingredientes tales como arándanos, uvas, alcachofas, cebollas, ajos, moras, ciruelas, manzanas, pescados, espinacas, coles, frutos secos e infusiones de té verde.

Incluir pescado azul en la dieta
Los pescados azules son muy ricos en omega 3, un ácido graso que cuida el corazón, reduce los niveles de colesterol malo en la sangre y, además, protege el organismo de las bacterias.
Si deseas incluir omega 3 en tu alimentación no te olvides de ingerir salmón, sardina, trucha, arenque y nueces con frecuencia.
Evitar el estrés
Llevar una dieta sana es fundamental para los hombres y mujeres que se preguntan cómo reducir los leucocitos altos, aunque es fundamental combinar una buena alimentación con otros buenos hábitos.
Y es que el estrés, el insomnio y el tabaco también influyen de una forma muy negativa en el cuerpo debido a que debilitan el sistema inmunológico y aumentan el número de leucocitos o glóbulos blancos en la sangre.
Dejar a un lado las grasas saturadas
Las personas que llevan una dieta rica en azúcares refinados, grasas saturadas, frituras y sal tienen un mayor riesgo de padecer sobrepeso u obesidad, enfermedades cardiovasculares y un exceso de colesterol.
Además, el consumo de estos ingredientes tan poco saludables también afecta al volumen de glóbulos blancos, por lo que resulta de gran importancia prescindir de ellos y sustituirlos por productos como las frutas, las verduras, los pescados, las carnes magras y los frutos secos.
Como ves, llevar una dieta sana y equilibrada, consumir antioxidantes y alimentos ricos en vitamina C y huir del estrés y el tabaco será vital si te planteas cómo reducir los leucocitos altos de forma natural y, al mismo tiempo, deseas disfrutar de una excelente salud mientras te mantienes joven durante mucho tiempo.
Fuente de este artículo: https://www.esalud.com/leucocitos-altos/
